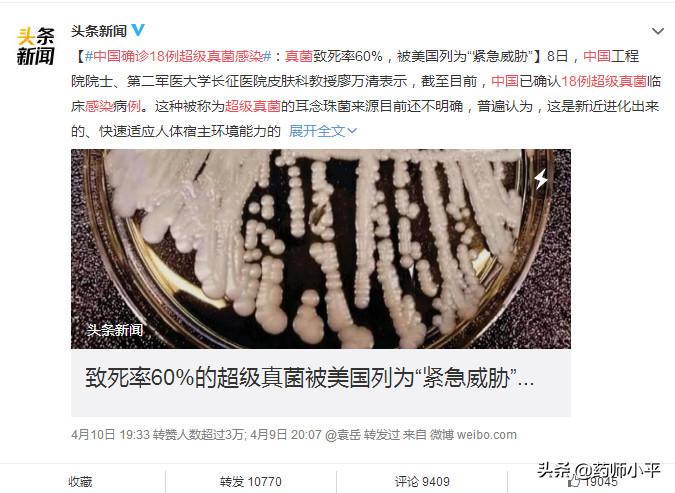
美国真菌感染死亡人数,美国超级真菌感染的症状

近日,网络上关于“超级真菌”耳念珠菌的新闻铺天盖地,引起了公共恐慌,实际的情况真的有那么恐怖吗,我们日常的生活的警示又是什么呢?
目前,耳念珠菌的来源尚不明确,感染者会有发高烧症状,并伴随各种器官衰竭、呼吸衰竭等表现。美国疾病控制与预防中心(CDC)已将耳念珠菌列入“紧急威胁”名单。
在《纽约时报》看来,耳念珠菌的爆发表明当今世界正面临着一种新的无法溯源的健康威胁,那就是不断增加的抗药性感染。
我会发现一些科普文中细菌和真菌混淆不清。
真菌属于真核细胞,有核孔复合物,胞浆中有细胞骨架微丝及各种细胞器。
查阅大量资料,尽力用大家都听得懂的话来讲明白这件事情。
什么是耳念珠菌?
耳念珠菌(Candida auris)是2009年日本科学家首次报道的一种致病的真菌(目前发现的致病真菌的种类有500多种,且这个数量在逐年增加)。

它属于真菌中的念珠菌,又因为是从人类外耳道分泌物中分离出的,就称它为耳念珠菌。当时分离出的耳念珠菌对抗真菌药物还是有效果的并不耐药。
尽管全球对耳念珠菌的研究已有近十年,但国内外学者对其来源、致病性和耐药性的形成仍然认识有限。国内研究耳念珠菌的主要是中国科学院微生物研究所黄广华研究员团队。

真菌感染有哪些种类?
真菌实际上满大街都是,按照感染的部位不同会分为浅部真菌感染和深部真菌感染。
浅部真菌感染主要大家特别熟悉一般也特别容易忽视的问题,比如足癣(俗称脚气)、甲真菌病(俗称灰指甲)、股癣(男性多见)、阴道炎等。

灰指甲
深部真菌感染一般会比较严重,组织中、血液中、甚至我们还遇到过在颅骨中感染真菌的。
最近我们遇到的一个是下肢组织的深部真菌感染,手术医生第一眼就高度怀疑,我们当时拍的照片如下:

下肢组织的真菌感染
随后入院进一步检查发现感染的也是念珠菌,具体哪种念珠菌目前还在检测中。

镜下真菌形态
为什么叫“超级真菌”?
通常具有多重耐药性,这意味着常用于治疗念珠菌感染的多种抗真菌药物抵抗不了。
美国疾病控制和预防中心(CDC)表示:大多数耳念珠菌菌株对至少一种抗真菌药物具有抗药性;超过三分之一的菌株对两种抗真菌药物具有抗药性;而部分菌株对所有三种抗真菌药物具有抗药性。
同时对耳念珠菌的鉴别存在一定困难,传统的生化鉴定方法很难鉴定超级真菌。

怎么检测到耳念珠菌?
目前主要使用质谱技术和分子生物学方法这两种。
据中国科学院微生物研究所黄广华研究员介绍,中国超级真菌临床感染病例报告延迟的主要原因可能是技术问题,质谱仪在中国大三甲医院以外并不十分普遍,不排除漏检的可能。在没有特定技术的情况下可能在实验室中被错误识别。
中国在2018年可以鉴定耳念珠菌。

“超级真菌”的危害?
近年来,“超级真菌”在全球不同国家快速传播,已造成严重的医院内感染。
病例变得特别多,目前包括美国、英国、法国、西班牙、委内瑞拉、墨西哥在内的30多个国家都出现了耳念珠菌,引起了世界多国学者的注意。

耳念珠菌全球分布图
国家卫健委抗菌药物临床应用与细菌耐药评价专家委员会办公室主任徐英春表示:
中文“超级真菌”,是由“超级病原”(“Superbug”)的词义引申而来。
“超级病原”一般指对多类抗菌药物耐药、甚至全部耐药的病原微生物。
目前耳念珠菌在国际上被冠以“超级病原”的称号,主要归因于以美国为主的地区所受到的临床威胁。
因此,关键是要快速识别住院患者的耳念珠菌,以便医疗机构可以采取预防措施来阻止其蔓延。我们需要警惕超级真菌的潜在威胁,早发现、早隔离、早治疗。
就没有药可杀死耳念珠菌吗?
由于抗生素的广泛应用和滥用免疫*制剂抑**、器官移植、血液透析和放化疗等的普遍使用,真菌感染的发病率逐年上升,已成为严重影响人们身体健康的公众问题。
第一个抗真菌药物两性霉素B问世以来,人类与真菌的斗争已持续半个多世纪。
合理的选择抗真菌药物对于真菌感染的治疗具有很重要的作用。
临床上常用的抗真菌药物主要有以下几种:
1、多烯烃类:代表药物为两性霉素B、制霉菌素。
2、唑类:代表药物有酮康唑、氟康唑、伊曲康唑、伏立康唑等。
3、烯丙胺类:代表药物有布替萘芬和特比萘芬,临床多用于浅部真菌感染。
4、棘白菌素类:对大多数念珠菌具有快速杀菌作用,包括一些对唑类耐药的菌株。
抗真菌药物研究进展的很缓慢,近年来,学者们也在逐步探索其他的一些药物有抗真菌的作用,比如胺碘酮是抗心律失常的也有抗真菌的作用。找不到合适的抗真菌的作用,慢慢的发现很多非抗真菌药物的抗真菌作用。
比起抗细菌和抗病毒的药物,抗真菌的药物真的是特别的少,如果对现有的药物都抵抗,那死亡率就特别高,这就是“超级真菌“的可怕之处。

耳念珠菌在中国的感染情况
中国第一株“超级真菌”耳念珠菌分离自一位76岁患有肾病综合征和高血压患者的支气管肺泡灌洗液。

耳念珠菌生长于卡玛嘉显色培养基上呈淡粉色
该株菌在显微镜下放大1000倍看到大量“细长瓜子样”孢子,看起来是不是很可爱呢?

耳念珠菌革兰染色后在显微镜下的形态
可别被表面的样子蒙蔽了,就这小样在42℃高温下,仍然会分泌大量的毒性因子(是一种很长的名字叫做天门冬氨酰蛋白酶Saps的东西),重要的是它会导致宿主组织损伤。
在覆盖我国230多家医疗机构的长期真菌病监测中,耳念珠菌的发生率还不到两万分之一;
在已经完成的全国范围67间ICU病房念珠菌血症的研究中,亦未分离到耳念珠菌;
我国尚未见耳念珠菌感染导致死亡的病例报道。
这说明,耳念珠菌在我国引起感染的发病率没有像网络上说的那么可怕,目前未出现像美国的暴发性流行感染。而且,我国发现的耳念珠菌属于不耐药的,即便感染了也有药可治。这下就放心了。
给到我们生活的警示?
目前耳念珠菌大规模暴发的可能性不大,但滥用抗生素的可怕后果不得不引起人们的重视。 超级耐药菌以及一些超级细菌(包括真菌)一直是医学界的难题,给人类医学和生存带来了很大挑战。 杜绝滥用抗生素,做到不随意买药、不自行选药、不任意服药、不随便停药。 需要各国共同努力,从我做起。从自己家人和孩子做起,大家 一起努力合理规范用药。 同时注意个人卫生,尤其是正确洗手,加强锻炼,合理膳食,注意休息,提高机体免疫力。
我是药师小平,写文不易,请多多支持。
您的转发、点评、点赞是对我最大的鼓励。谢谢你哦!
#这很科学# #头条辟谣# #真相来了#